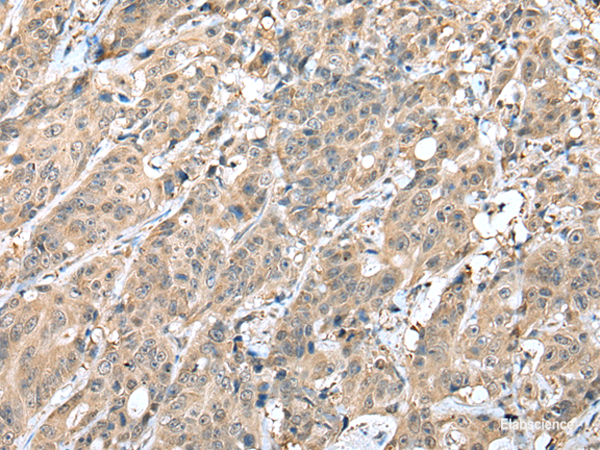
Anti-HIF1A

Cookie-Einstellungen
Diese Website benutzt Cookies, die für den technischen Betrieb der Website erforderlich sind und stets gesetzt werden. Andere Cookies, die den Komfort bei Benutzung dieser Website erhöhen, der Direktwerbung dienen oder die Interaktion mit anderen Websites und sozialen Netzwerken vereinfachen sollen, werden nur mit Ihrer Zustimmung gesetzt.
Konfiguration
Technisch erforderlich
Diese Cookies sind für die Grundfunktionen des Shops notwendig.
"Alle Cookies ablehnen" Cookie
"Alle Cookies annehmen" Cookie
Ausgewählter Shop
CSRF-Token
Cookie-Einstellungen
FACT-Finder Tracking
Individuelle Preise
Kundenspezifisches Caching
Session
Währungswechsel
Komfortfunktionen
Diese Cookies werden genutzt um das Einkaufserlebnis noch ansprechender zu gestalten, beispielsweise für die Wiedererkennung des Besuchers.
Facebook-Seite in der rechten Blog - Sidebar anzeigen
Merkzettel
Statistik & Tracking
Endgeräteerkennung
Kauf- und Surfverhalten mit Google Tag Manager
Partnerprogramm
Bei Fragen nutzen Sie gerne unser Kontaktformular.
Bestellen Sie auch per E-Mail: info@biomol.com
Größere Menge gewünscht? Bulk-Anfrage
Bestellen Sie auch per E-Mail: info@biomol.com
Größere Menge gewünscht? Bulk-Anfrage
This gene encodes the alpha subunit of transcription factor hypoxia-inducible factor-1 (HIF-1),... mehr
Produktinformationen "Anti-HIF1A"
This gene encodes the alpha subunit of transcription factor hypoxia-inducible factor-1 (HIF-1), which is a heterodimer composed of an alpha and a beta subunit. HIF-1 functions as a master regulator of cellular and systemic homeostatic response to hypoxia by activating transcription of many genes, including those involved in energy metabolism, angiogenesis, apoptosis, and other genes whose protein products increase oxygen delivery or facilitate metabolic adaptation to hypoxia. HIF-1 thus plays an essential role in embryonic vascularization, tumor angiogenesis and pathophysiology of ischemic disease. Protein function: Functions as a master transcriptional regulator of the adaptive response to hypoxia. Under hypoxic conditions, activates the transcription of over 40 genes, including erythropoietin, glucose transporters, glycolytic enzymes, vascular endothelial growth factor, HILPDA, and other genes whose protein products increase oxygen delivery or facilitate metabolic adaptation to hypoxia. Plays an essential role in embryonic vascularization, tumor angiogenesis and pathophysiology of ischemic disease. Heterodimerizes with ARNT, heterodimer binds to core DNA sequence 5'-TACGTG-3' within the hypoxia response element (HRE) of target gene promoters. Activation requires recruitment of transcriptional coactivators such as CREBBP and EP300. Activity is enhanced by interaction with both, NCOA1 or NCOA2. Interaction with redox regulatory protein APEX seems to activate CTAD and potentiates activation by NCOA1 and CREBBP. Involved in the axonal distribution and transport of mitochondria in neurons during hypoxia. [The UniProt Consortium]
| Schlagworte: | Anti-BHLHE78, Anti-bHLHe78, Anti-HIF1-alpha, Anti-HIF-1-alpha, Anti-Member of PAS protein 1, Anti-ARNT-interacting protein, Anti-PAS domain-containing protein 8, Anti-Hypoxia-inducible factor 1-alpha, Anti-Basic-helix-loop-helix-PAS protein MOP1, HIF1A Po |
| Hersteller: | Elabscience |
| Hersteller-Nr: | E-AB-52265 |
Eigenschaften
| Anwendung: | IHC, ELISA |
| Antikörper-Typ: | Polyclonal |
| Konjugat: | No |
| Wirt: | Rabbit |
| Spezies-Reaktivität: | human, mouse |
| Immunogen: | Fusion protein of human HIF1A |
Datenbank Information
| KEGG ID : | K08268 | Passende Produkte |
| UniProt ID : | Q16665 | Passende Produkte |
| Gene ID : | GeneID 3091 | Passende Produkte |
Handhabung & Sicherheit
| Lagerung: | -20°C |
| Versand: | 4°C (International: -20°C) |
Achtung
Nur für Forschungszwecke und Laboruntersuchungen: Nicht für die Anwendung im oder am Menschen!
Nur für Forschungszwecke und Laboruntersuchungen: Nicht für die Anwendung im oder am Menschen!
Hier folgen Informationen zur Produktreferenz.
mehr
Hier kriegen Sie ein Zertifikat
Loggen Sie sich ein oder registrieren Sie sich, um Analysenzertifikate anzufordern.
Bewertungen lesen, schreiben und diskutieren... mehr
Kundenbewertungen für "Anti-HIF1A"
Bewertung schreiben
Loggen Sie sich ein oder registrieren Sie sich, um eine Produktbewertung abzugeben.
Zuletzt angesehen